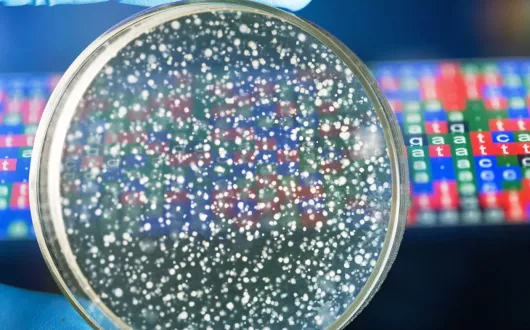
Petri

Jest nam niezmiernie miło poinformować, że mgr inż. Marcin Sypka otrzymał finansowanie w ramach konkursu NCN PRELUDIUM 24 dla projektu pt. "ANTARCTICKER: Molekularny mechanizm degradacji odpadów keratynowych z użyciem antarktycznych bakterii oraz charakterystyka jego bioaktywnych produktów.". Gratulujemy!
Data dodania
Kategorie
Jest nam niezmiernie miło poinformować, że Pani mgr inż. Dominika Nielipińska otrzymała nagrodę Oddziału Łódzkiego Polskiego Towarzystwa Chemicznego za najlepszą prezentację ustną podsumowującą dotychczasowe wyniki swojego projektu realizowanego w ramach studiów doktoranckich. Z kolei Pani Joanna Brzezińska zdobyła nagrodę Instytutu Biologii Medycznej PAN za najlepszą prezentację posterową z pogranicza chemii i biologii. Poster przedstawiał wyniki projektu magisterskiego realizowanego we współpracy z Centrum Badań Molekularnych i Makromolekularnych PAN. Serdecznie gratulujemy i życzymy dalszych sukcesów!
Data dodania
Kategorie
Jest nam niezmiernie miło poinformować, że dr inż. Marcin Szustak otrzymał finansowanie w ramach konkursu NCN MINIATURA 8 dla projektu "Erytrytol i ksylitol oraz ich potencjalny wpływ na reaktywność płytek krwi". Gratulujemy!
Data dodania
Kategorie
20 grudnia 2024 mgr inż Eliza Korkus obroniła swoją rozprawę doktorską nt. „Związki lipidowe zawarte w owocach rokitnika zwyczajnego (Hippophae rhamnoides L.) jako ligandy receptorów sprzężonych z białkiem G zaangażowanych w utrzymanie homeostazy glukozy”. Promotorem pracy była dr hab. Edyta Gendaszewska-Darmach, prof. uczelni. Gratulujemy!
Data dodania
Kategorie
Prof. Maria Koziołkiewicz oraz dr hab. inż Aneta Białkowska 16 grudnia odebrały statuetki w plebiscycie organizowanym przez Samorząd Studencki PŁ na Najlepszego nauczyciela w 2024 roku. Gratulujemy!
Data dodania
Kategorie
Prof. Maria Koziołkiewicz w kolejnej rozmowie z cyklu "Smaki nauki" wyjaśnia, w jaki sposób dieta wpływa na genom człowieka. Ekspertka oraz prowadząca, dr inż. Ilona Gałązka-Czarnecka, są badaczkami na Wydziale Biotechnologii i Nauk o Żywności PŁ.
Data dodania
Kategorie
Nauczyciele IBMiP wśród zwycięzców i nominowanych w plebiscycie na najlepszego nauczyciela w roku aka. 2022/2023!
Data dodania
Kategorie
Prof. Maria Koziołkiewicz na temat współczesnych problemów z niedoborem witaminy D.
Data dodania
Kategorie
Rozmowa z badaczkami z Zespołu bioaktywnych fitozwiązków i nutrigenomiki o diecie
Data dodania
Kategorie
Dr inż. Agnieszka Pietrzyk-Brzezińska i uzyskała prawie 50 tys. na Analizę oddziaływań regulatora odpowiedzi na cefalosporyny i chloramfenikol z efektorami i DNA.